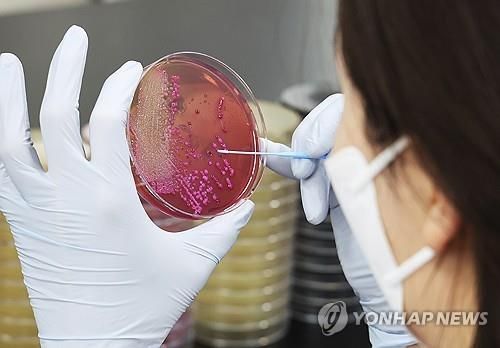
무더운 날씨 식중독 조심하세요

(횡성=연합뉴스) 임보연 기자 = 횡성군 보건소는 올여름 식중독 발생 예방을 위해 '2025년 식중독 예방 맞춤형 컨설팅 사업'을 본격 시행한다고 16일 밝혔다.
이번 사업은 김밥, 냉면, 생선회, 육회 등 여름철 식중독 위험이 큰 음식을 취급하는 음식점과 뷔페, 군부대 등을 대상으로 위생 점검과 개선을 지원한다.
횡성군은 조리 과정 전반에 걸쳐 식재료 보관부터 조리·배식까지 단계별 위생 상태를 꼼꼼히 확인하고 ATP 위생 검사와 도구 표면 청결도 검사 등 과학적 방법을 활용해 오염 위험 요소를 찾아낸다.
아울러 세척제 잔류 여부 및 개인 위생관리 준수 여부도 집중적으로 점검할 예정이다.
이와 함께 식중독 예방 효과를 높이기 위해 위생 점검과 동시에 다양한 수거검사도 병행 실시한다.
이를 통해 식품의 안전성 여부를 체계적으로 확인하고, 문제 발생 시 신속한 대응 체계를 구축할 계획이다.
컨설팅 후에는 각 업소를 대상으로 실무에 바로 적용할 수 있는 위생관리 개선 방안을 제안하고, 조리 환경에서 유용하게 활용할 소독제 등 홍보 물품을 지원해 실질적인 위생 수준 향상을 도울 예정이다.
김영대 횡성군보건소장은 "식중독 예방을 위해 특히 취약한 영업장에 맞춤형 위생 점검과 교육, 철저한 수거검사를 지속해 안심하고 식사할 수 있는 환경 조성에 최선을 다하겠다"고 말했다.
limbo@yna.co.kr
Copyright ⓒ 연합뉴스 무단 전재 및 재배포 금지
본 콘텐츠는 뉴스픽 파트너스에서 공유된 콘텐츠입니다.